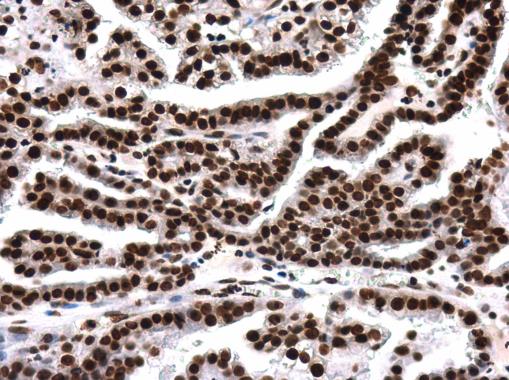
产品封面图

相关产品推荐更多 >
万千商家帮你免费找货
0 人在求购买到急需产品
- 详细信息
- 文献和实验
- 技术资料
- 免疫原:
Carrier-protein conjugated synthetic peptide surrounding acetyl Lys8 of human Histone H4. The exact sequence is proprietary.
- 亚型:
IgG3
- 形态:
Liquid
- 保存条件:
Store as concentrated solution. Centrifuge briefly prior to opening vial. For short-term storage (1-2 weeks), store at 4ºC. For long-term storage, aliquot and store at -20ºC or below. Avoid multiple freeze-thaw cycles.
- 克隆性:
Monoclonal
- 标记物:
Unconjugated
- 适应物种:
Human, Mouse, Rat
- 保质期:
12 months from the shipping date of the product.
- 抗原来源:
Human
- 目录编号:
GTX633420
- 级别:
Primary Antibodies
- 库存:
Available
- 供应商:
GeneTex
- 宿主:
Mouse
- 应用范围:
WB, ICC/IF, IHC-P
- 浓度:
0.95 mg/ml (Please refer to the vial label for the specific concentration.)
- 靶点:
Histone H4K8ac (acetyl Lys8)
- 抗体英文名:
Histone H4K8ac (acetyl Lys8) antibody [GT478]
- 抗体名:
Histone H4K8ac (acetyl Lys8) 抗体 [GT478]
- 规格:
100 μl/25 μl
| 规格: | 100 μl | 产品价格: | ¥4000.0 |
|---|---|---|---|
| 规格: | 25 μl | 产品价格: | ¥1700.0 |
Histone H4K8ac (acetyl Lys8) antibody [GT478] detects Histone H4K8ac (acetyl Lys8) protein at cytoplasm and nucleus in rat kidney by immunohistochemical analysis.
Sample: Paraffin-embedded rat kidney.
Histone H4K8ac (acetyl Lys8) antibody [GT478] (GTX633420) diluted at 1:200.
Antigen Retrieval: Citrate buffer, pH 6.0, 15 min
Histone H4K8ac (acetyl Lys8) antibody [GT478] detects Histone H4K8ac (acetyl Lys8) protein at nucleus by immunofluorescent analysis.
Sample: HeLa cells were fixed in 4% PFA at RT for 15 min.
Green: Histone H4K8ac (acetyl Lys8) protein stained by Histone H4K8ac (acetyl Lys8) antibody [GT478] (GTX633420) diluted at 1:400.
Red: alpha Tubulin, a cytoskeleton marker, stained by alpha Tubulin antibody (GTX102078) diluted at 1:300.
Scale bar = 10 μm.
Untreated (–) and treated (+) HeLa whole cell extracts (30 μg) were separated by 15% SDS-PAGE, and the membrane was blotted with Histone H4K8ac (acetyl Lys8) antibody (GTX633420) diluted at 1:1000.
Histone H4K8ac (acetyl Lys8) antibody [GT478] detects Histone H4K8ac (acetyl Lys8) protein at nucleus in human ovary by immunohistochemical analysis.
Sample: Paraffin-embedded human ovary.
Histone H4K8ac (acetyl Lys8) antibody [GT478] (GTX633420) diluted at 1:200.
Antigen Retrieval: Citrate buffer, pH 6.0, 15 min
Histone H4K8ac (acetyl Lys8) antibody [GT478] detects Histone H4K8ac (acetyl Lys8) protein at cytoplasm and nucleus in mouse brain by immunohistochemical analysis.
Sample: Paraffin-embedded mouse brain.
Histone H4K8ac (acetyl Lys8) antibody [GT478] (GTX633420) diluted at 1:200.
Antigen Retrieval: Citrate buffer, pH 6.0, 15 min
风险提示:丁香通仅作为第三方平台,为商家信息发布提供平台空间。用户咨询产品时请注意保护个人信息及财产安全,合理判断,谨慎选购商品,商家和用户对交易行为负责。对于医疗器械类产品,请先查证核实企业经营资质和医疗器械产品注册证情况。
文献和实验Samata M et al., Cell 2020 (PMID:32502394)
,为此CST公司推出了可用于蛋白功能检测的乙酰化组蛋白系列抗体,圆满的解决这个问题。因为乙酰化与蛋白的活性相关,因此通过乙酰化的系列抗体特异性地识别靶蛋白的乙酰化形式,可以反映出靶蛋白质的活性水平,达到研究蛋白功能和调节的目的。而其他的抗体仅能反映出该蛋白质的表达量或表达水平,不能反映出蛋白的活性状态。乙酰化系列抗体:Catalog#Product DescriptionSourceApplications2576Acetyl-Histone H2A (Lys5) AntibodyRabbitW IP
Identifying Acetylated Proteins in Mitosis
the acetylation status of several mitotic proteins by anti-acetyl-Lysine immunoprecipitation with a monoclonal antibody followed by Western blot analyses of the proteins of interest. We further confirmed by a reciprocal immunoprecipitation with protein-specific
Synthesis and Probing of Membrane-bound Peptide Arrays
should be Cys(Acm) or Cys(Trt), Asp(OtBu), Glu(OtBu), His(Trt), Lys(Boc), Asn(Trt), Gln(Trt), Arg(Pmc), Ser(tBu), Thr(tBu), Trp(Boc), and Tyr(tBu). HOBt-esters of these amino acid derivatives must be prepared in NMP for use throughout in spotting reactions
技术资料暂无技术资料 索取技术资料

![CD86 antibody [1B3]](https://img1.dxycdn.com/2022/0328/873/3270455114817500453-14.jpg!wh200)
